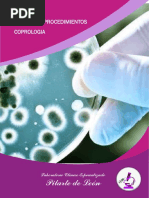

PORTADA AUTORES
Anna Merino
TÍTULO
Manual de Citología de Sangre Periférica y
Líquidos Biológicos
SUBTÍTULO
CARACTERÍSTICAS TÉCNICAS
– EAN 9788491102632 – DIMENSIONES
– PÁGINAS 280 – EDICIÓN 2
– ENCUADERNACIÓN Versión – AÑO 2020
Digital
PUNTOS CLAVES
Describe minuciosamente las células sanguíneas normales y patológicas que pueden pasar a la
circulación.
Incluye un capítulo dedicado a distintos microorganismos y parásitos causantes de patologías
emergentes como consecuencia del fenómeno migratorio.
Contiene abundante iconografía, representativa de la mayoría de los procesos hematológicos que
tienen una traducción periférica.
Hace referencia a la utilidad de técnicas complementarias como la citoquímica, inmunocitología o la
microscopia electrónica en situaciones patológicas concretas.
DESCRIPCIÓN
En la actualidad, el diagnóstico de más del 80% de las enfermedades hematológicas se consigue mediante
un examen morfológico que debe tener como punto de partida el estudio de la sangre periférica. Una
buena formación en citología de la sangre periférica y líquidos biológicos es imprescindible ya que el
examen morfológico de los elementos que forman parte de la sangre constituye el eslabón analítico inicial
de numerosas patologías.
Libro avalado por la SEQC(ML) - Sociedad Española de Medicina de Laboratorio.
DIRIGIDO A
Manual de citología de sangre periférica y líquidos biológicos es un título imprescindible para todos
aquellos profesionales de la sanidad que están en periodo de especialización hematológica o cuya labor
esté relacionada con el laboratorio de hematología (médicos, biólogos, farmacéuticos o químicos;
especialistas en hematología y hemoterapia, análisis clínicos o bioquímica clínica y diplomados en
enfermería o técnicos de laboratorio).
T E LÉ FONO E M A IL
( 54- 11) 4821- 5520 cin f o @ m e d ica p a n a m e r ica n a . co m
© 2 0 2 0 E DI T O R I AL M É DI C A P AN AM E R I C AN A. T O DO S L O S DE R E C H O S R E SE R V ADO S
�CONTENIDO
3 Microorganismos y parásitos en sangre
1 Hematopoyesis y células sanguíneas periférica
Origen de las células de sangre periférica Infecciones por bacterias
Examen citológico de sangre periférica Infecciones por parásitos intracelulares
Elementos celulares de sangre periférica Infecciones por parásitos extracelulares
flagelados
Etapas de diferenciación de la serie
eritroblástica Infecciones por Helmintos
Etapas de diferenciación de la serie Infecciones por hongos
granulocítica
4 Alteraciones de las plaquetas en sangre
Etapas de diferenciación monocítica
periférica
Recuento celular. Parámetros
hematológicos básicos Morfología de las plaquetas
Células progenitoras y cultivos celulares Alteraciones cuantitativas de las plaquetas
Separación de las células mononucleadas Alteraciones adquiridas de las plaquetas
de sangre periférica mediante técnica de
Alteraciones congénitas de las plaquetas
Ficoll
Reacciones citoquímicas y su contribución 5 Diagnóstico diferencial de las anemias
a la identificación de las células
sanguíneas Introducción
Análisis citogenético de las células Anemias carenciales
sanguíneas
Hemoglobinopatías
Análisis inmunofenotípico de las células
sanguíneas Anemias hemolíticas congénitas
Anemias hemolíticas adquiridas
2 Alteraciones morfológicas eritrocitarias y
leucocitarias
Morfología eritrocitaria en el diagnóstico
de anemia
Alteraciones morfológicas de la serie roja
6 Síndromes mielodisplásicos y neoplasias
Alteraciones morfológicas de la serie
mielodisplásicas/mieloproliferativas
granulocítica
Alteraciones cuantitativas de la Síndromes mielodisplásicos
granulopoyesis
Neoplasias mielodisplásicas
Alteraciones morfológicas de los linfocitos /mieloproliferativas
Alteraciones morfológicas de los monocitos 7 Neoplasias mieloproliferativas
Macrófagos y fagocitosis Clasificación de las neoplasias
mieloproliferativas
Células no hematopoyéticas circulantes
T E LÉ FONO E M A IL
( 54- 11) 4821- 5520 cin f o @ m e d ica p a n a m e r ica n a . co m
© 2 0 2 0 E DI T O R I AL M É DI C A P AN AM E R I C AN A. T O DO S L O S DE R E C H O S R E SE R V ADO S
� Leucemia mieloide crónica BCR‑ABL1 Diagnóstico morfológico diferencial entre
positiva las células mesoteliales reactivas o
benignas y las células neoplásicas
Leucemia neutrofílica crónica malignas
Policitemia vera Valores de referencia
Mielofibrosis primaria Otros hallazgos en el examen citológico de
líquidos biológicos
Trombocitemia esencial
Estudio del líquido pleural
Leucemia eosinofílica crónica no
especificada Características citológicas específicas de
enfermedades no neoplásicas en líquido
Neoplasia mieloproliferativa inclasificable pleural
8 Diagnóstico diferencial de las leucemias Características citológicas específicas de
agudas las células neoplásicas en líquido pleural
Introducción Características citológicas específicas de
las células no neoplásicas en líquido
Clasificación de las leucemias mieloides ascítico
agudas
Características citológicas específicas de
Clasificación de las leucemias mieloides las células neoplásicas en líquido ascítico
agudas según la OMS (2016)
Cristales en líquido ascítico
Neoplasias de precursores linfoides
Levaduras en líquido ascítico
9 Neoplasias linfoides B y T maduras
Estudio del líquido cefalorraquídeo
Introducción Características citológicas del líquido
cefalorraquídeo
Folículo linfoide
Criptococos, neumococos y toxoplasma en
Neoplasias linfoides B y T maduras líquido cefalorraquídeo
10 Citología de líquidos biológicos (serosos Cristales y liposomas en el líquido
y cefalorraquídeo) y su utilidad diagnóstica cefalorraquídeo
Introducción Estudio del líquido articular
Recuento celular Características citológicas de las células
del líquido articular
Obtención de las muestras, citocentrífuga
y examen citológico Cristales en el líquido articular
Derrames serosos y células normales Estudio del líquido pericárdico
Células benignas en líquidos biológicos Estudio citológico del líquido pericárdico
T E LÉ FONO E M A IL
( 54- 11) 4821- 5520 cin f o @ m e d ica p a n a m e r ica n a . co m
© 2 0 2 0 E DI T O R I AL M É DI C A P AN AM E R I C AN A. T O DO S L O S DE R E C H O S R E SE R V ADO S